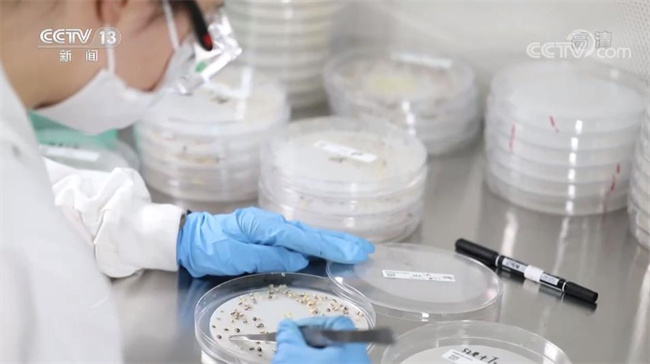

央视网消息(焦点访谈):民以食为天,农业是一切发展的基础。今天(8月26日)开始,《焦点访谈》将播出系列节目《餐桌内外看变化》,我们先来关注种子。一粒种子,包含成千上万的遗传密码,被称为农业的“芯片”。这米饭香不香、大豆能出多少油、玉米糯不糯、水果甜不甜,种子是关键。中国种子都来自哪里?优质品种是怎么培育的?又该如何保障好中国人的粮食安全呢?今天通过剖析一粒玉米种子,来体验如何打造中国农业“芯片”。

盛夏,北京郊区的这片农田里,幼儿园的老师们正带着孩子,收获今年春天他们自己种下的玉米。
玉米,原产南美,500年前传入中国后,逐渐成为中国人最主要的口粮之一。现在,中国人每年要吃掉接近1000万吨玉米,大家对玉米的需求,早已不只是填饱肚子那么简单。
今天,消费者在菜场、超市里挑选的各类玉米,很少是农民自己留种种出来的,大多都是育种专家们选育的品种。

目前在我国,杂交育种仍是农作物最主要的育种方式。想要培育出一款又甜又糯的玉米,首先就要找到优质的甜玉米和糯玉米。对育种专家来说,找到携带优质基因的父本和母本,是育出好种的最大前提。
在位于中国农业科学院的国家作物种质库里,李立会正和团队人员一起查看刚刚从全国各地收集来的种子。这里是中国农作物种质资源战略保存中心,除了保存在各地种质圃中的多年生、无性繁殖以及野生资源外,这里保存着45万余份农作物种质资源,光玉米种质资源就有三万多份。农作物种质资源,也是农作物的遗传资源、基因资源,决定着农作物的所有特征性状。
此前,我国曾先后在上世纪50年代和80年代开展过两次农作物种质资源普查,收集保护了一大批珍稀、重要资源,但当时普查并不全面,还有不少品种散落在各地。2015年,农业部启动了第三次全国农作物种质资源普查与收集行动。
保护种质资源,就是保护我们农业“芯片”的根本。放眼世界,每个农业强国,都需要拥有强大的种质库。

截至今年6月,第三次农作物种质资源普查已经收集到了11.3万份种质资源。这些新收集的种子,将在田间种植2—3年,定期观测记录,鉴定确认为独一无二的特征后,最终形成一份包含30多项表型特征的“身份证”然后入库。
就在去年,国家作物种质库新库开始试运行。在这里,每一份种子将能保存50年,在这期间,这里的科学家们将持续对它们进行基因测序、深入探究这些种子的遗传奥秘,也为全国的育种专家们提供育种资源,让中国种子的研发掌握在中国人自己的手中。
在我国,玉米不但是重要的口粮,更是主要的动物饲料和重要的工业原料,国内玉米产量一直存在缺口。增产是这些年玉米育种的一个重要方向。

夏末,在北京顺义的试验田里,黎亮和学生们正在和新培育的玉米品种进行一场特殊的拔河比赛。把玉米茎秆拉到一定角度,精确测量所需要的拉力,就可以直观地看到,这个试验品种抗倒伏的能力有多强。
玉米要提高亩产,提高种植密度是主要途径,但是种植太密,很容易发生倒伏。
黎亮和他的学生们正在培育的这个玉米品种,是一个高产又不易倒伏,适合机器收获的品种,它的抗倒性,正是来自国家作物种质库中保存的遗传资源。
在田间,黎亮一直随身携带着平板电脑,每一株玉米都有一个二维码,他只要轻轻一扫,就能看到这株玉米的所有信息。
在这个试验田里,每个玉米品种只种植一行,两亩地里一共种着1000多个不同品种的玉米。在它们当中,最让黎亮惦记的是这几株看起来不起眼的玉米,被叫作“单倍体诱导系”,它本身并不携带增产抗虫等优质基因,但却能大大缩短中国育种专家们育种的时间。
从种质资源创新到育种技术创新,中国育种专家们深耕农作物育种基础创新,让中国育种从1.0时代逐渐向世界最先进的4.0时代追赶。
中国科学院院士、中国农业科学院作物科学研究所所长钱前说:“育种进步是跟着国家科技进步一起的,第一个阶段是农民育种,在田间发现好的;第二是上世纪20年代、30年代开始使用杂交育种;第三是知道性状怎么控制,遗传基因在哪个区域里面,进行分子标记辅助选育;现在做到4.0,生物育种,逐渐开始成为主流,从随机到定向选择。”
随着技术的进步,中国农作物种子国产率也不断提升,目前,我国农作物自主选育品种面积占比超过95%,“中国粮”基本都用上了“中国种”,粮食产量近年来屡创新高。在这背后,还有中国育种专家们不断继续创新的努力。

海南三亚,在北方只能种植一季的作物,可以在这里实现两季甚至三季种植,吸引了来自全国各地的育种专家。
滕文涛是一家种业研发企业玉米种业研发人员,他拍摄的这段视频,正在给外地的同事介绍今年不同玉米品种在海南种植的最新情况。
草地贪夜蛾是来自美洲的玉米天敌,两年前开始迁徙到亚洲,已经成了中国南方玉米种植最大的虫害。远在陕西杨凌的育种团队仔细观看他发回的视频。
以往,面对农作物虫害,大多只能通过喷洒农药应对,但这样不仅容易增加农药残留,而且害虫耐药后防虫效果也会不断降低,如果能通过生物育种技术,培育出“虫子不喜欢吃”的玉米,既能减少农药带来的副作用,害虫的耐药性也能有所减缓。

然而,不论用什么方法育种,在试验阶段,育种专家们都要面临成千上万粒性状不同的种子,怎么能从这上万粒种子中,找到最抗虫的那一粒呢?
在陕西杨凌高新技术区,企业专门建设了一个现代育种工厂,在这里,通过生物育种得到的种子都要先在这个检测设备中做一个扫描,育种专家解读种子的遗传信息后,留下最可能发挥抗虫作用的种子种入试验田里。
中国中化种业玉米研发团队负责人徐加新说:“育种就是一个预测的科学,从大海里面捞鱼,要抓到最好的一条,一般第一步会保留35%,其他的就可以淘汰,这样在下地之前就可以虚拟预测了,一般的育种可能需要3年的时间,现在因为有数据依据,有这些技术,缩短1到2年的时间。”
在这个育种工厂,每年可以检测二三十万份种子,加上单倍体技术快速育种,两年不到的时间内,企业就培育出了几个虫子不喜欢吃产量又高的品种,在温室种植后表现很好。
不过,抗虫新品种究竟是否有用,还要经过大田里的测试。在海南育种的滕文涛,也把这个新的玉米品种在测试大田里的表现及时反馈了回来。

在培育这个种子的过程中,从抗病虫性状的寻找到新品种的培育,背后是成百上千名种子科学家的努力,每一步都由创新技术来驱动。
十年来,国内科研院所育种企业不断加大研发投入,我国每年审定的玉米品种数量不断增加。
一粒玉米种子,外表看去并不起眼,却汇集了诸多创新。农业现代化,种子是基础,必须把民族种业搞上去,把种源安全提升到关系国家安全的战略高度,集中力量破难题、补短板、强优势、控风险,实现种业科技自立自强、种源自主可控。从种子入手,在种质资源、育种技术上不断创新,打好种业翻身仗,让种业装上更多“中国芯”,我们才能把饭碗端得更牢、更好。





